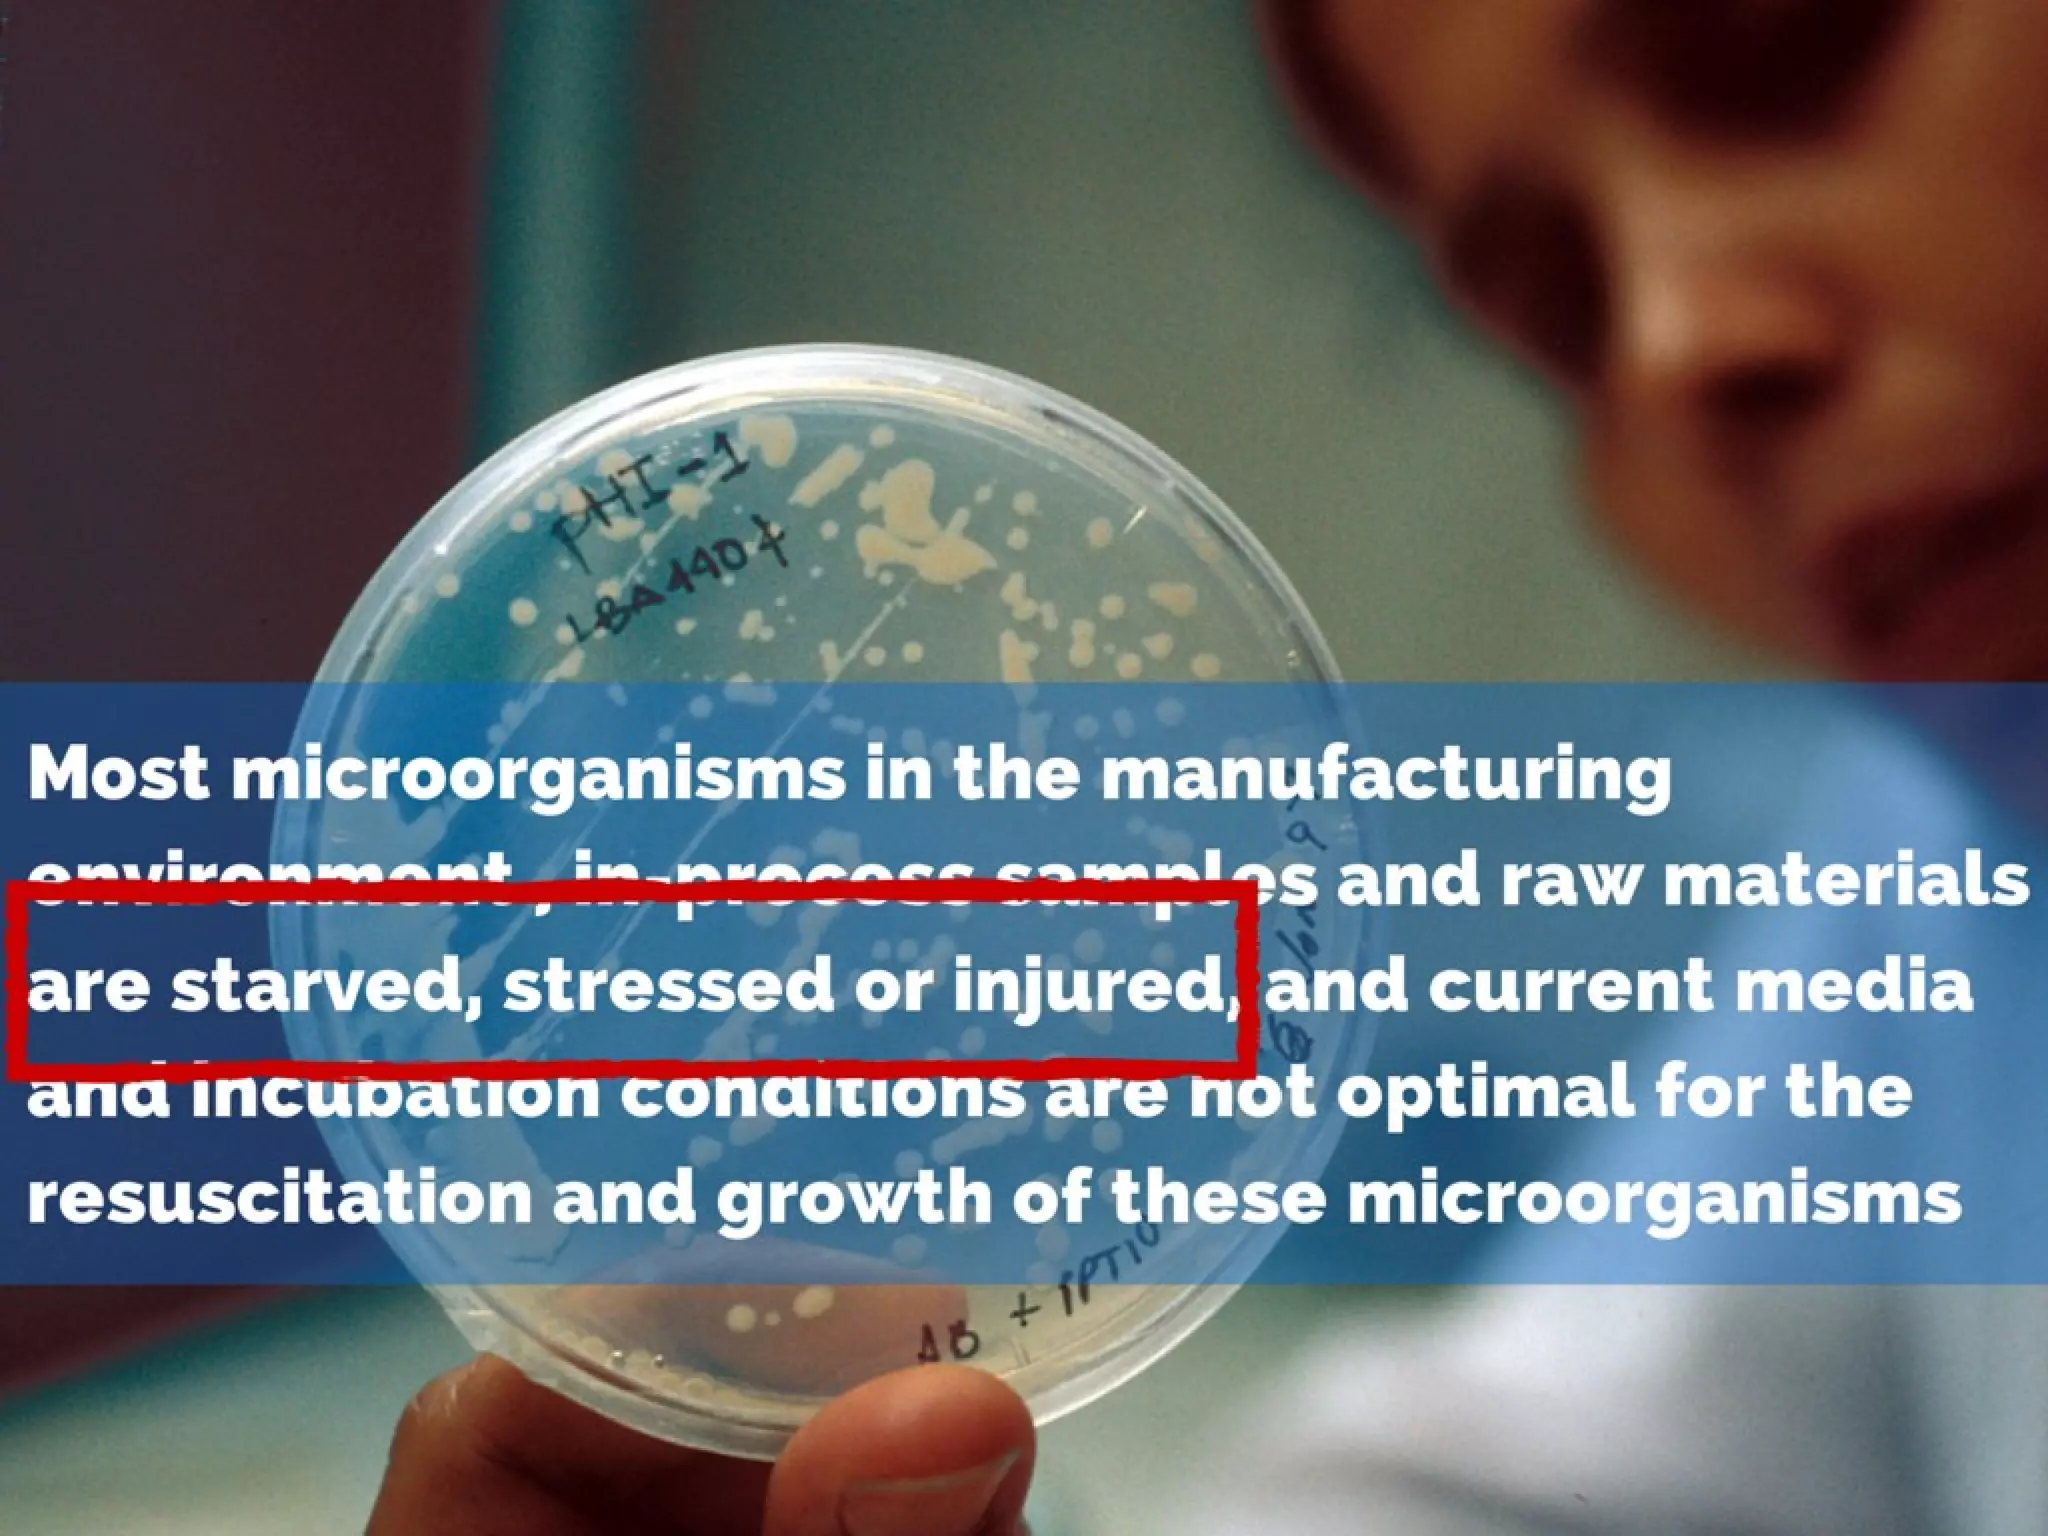
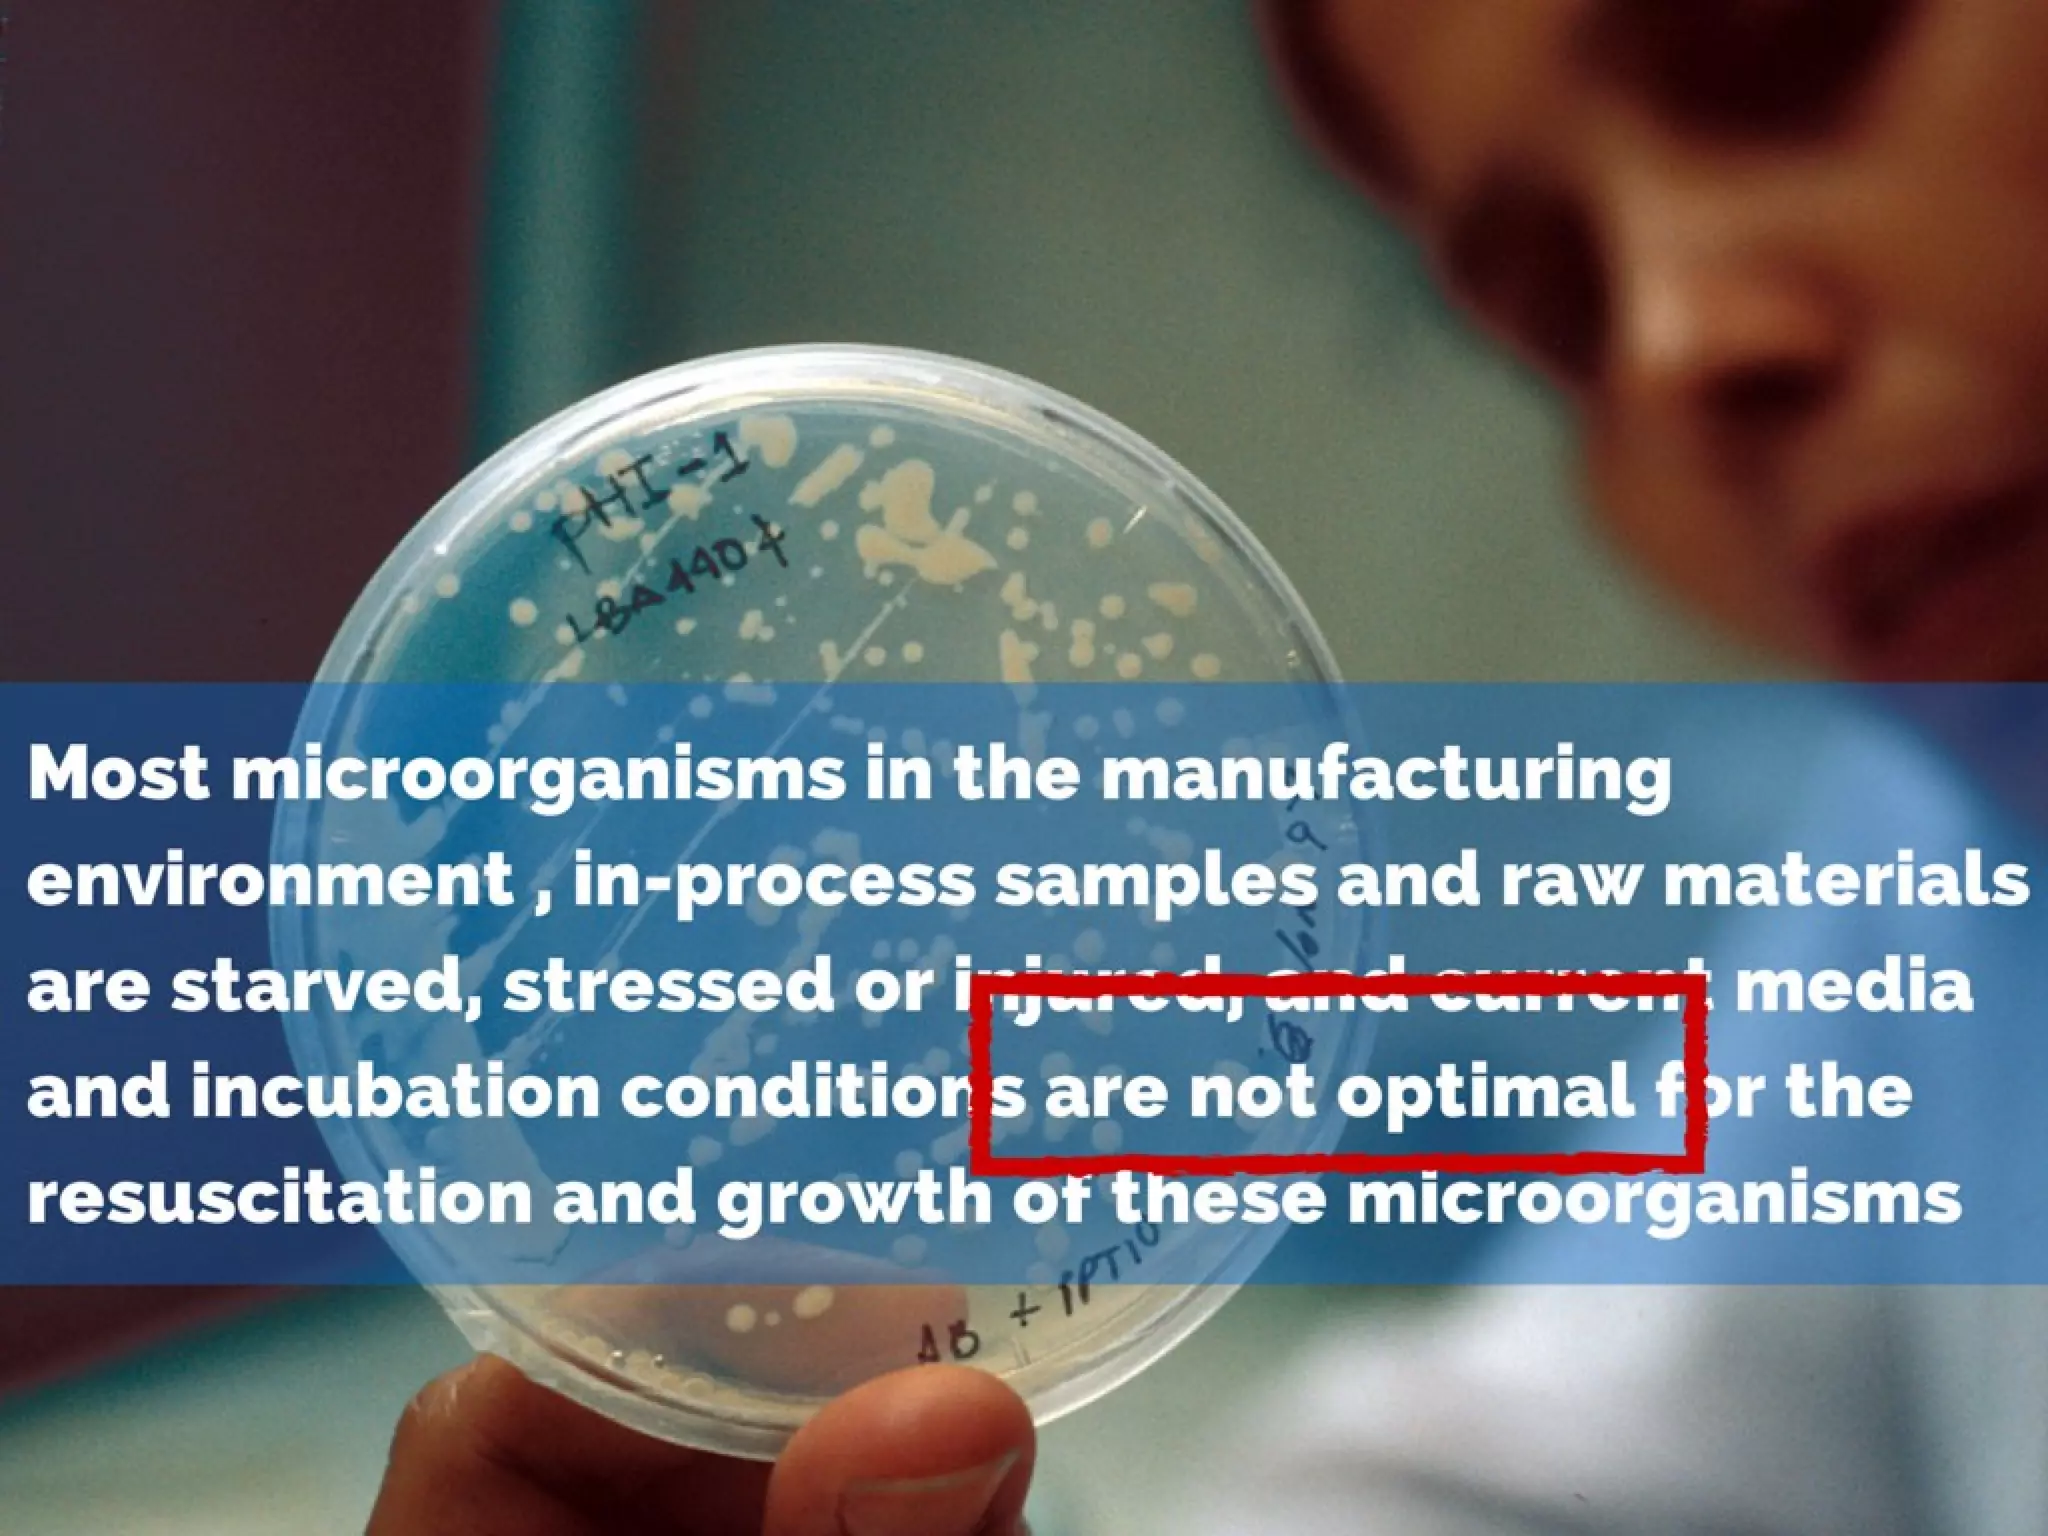
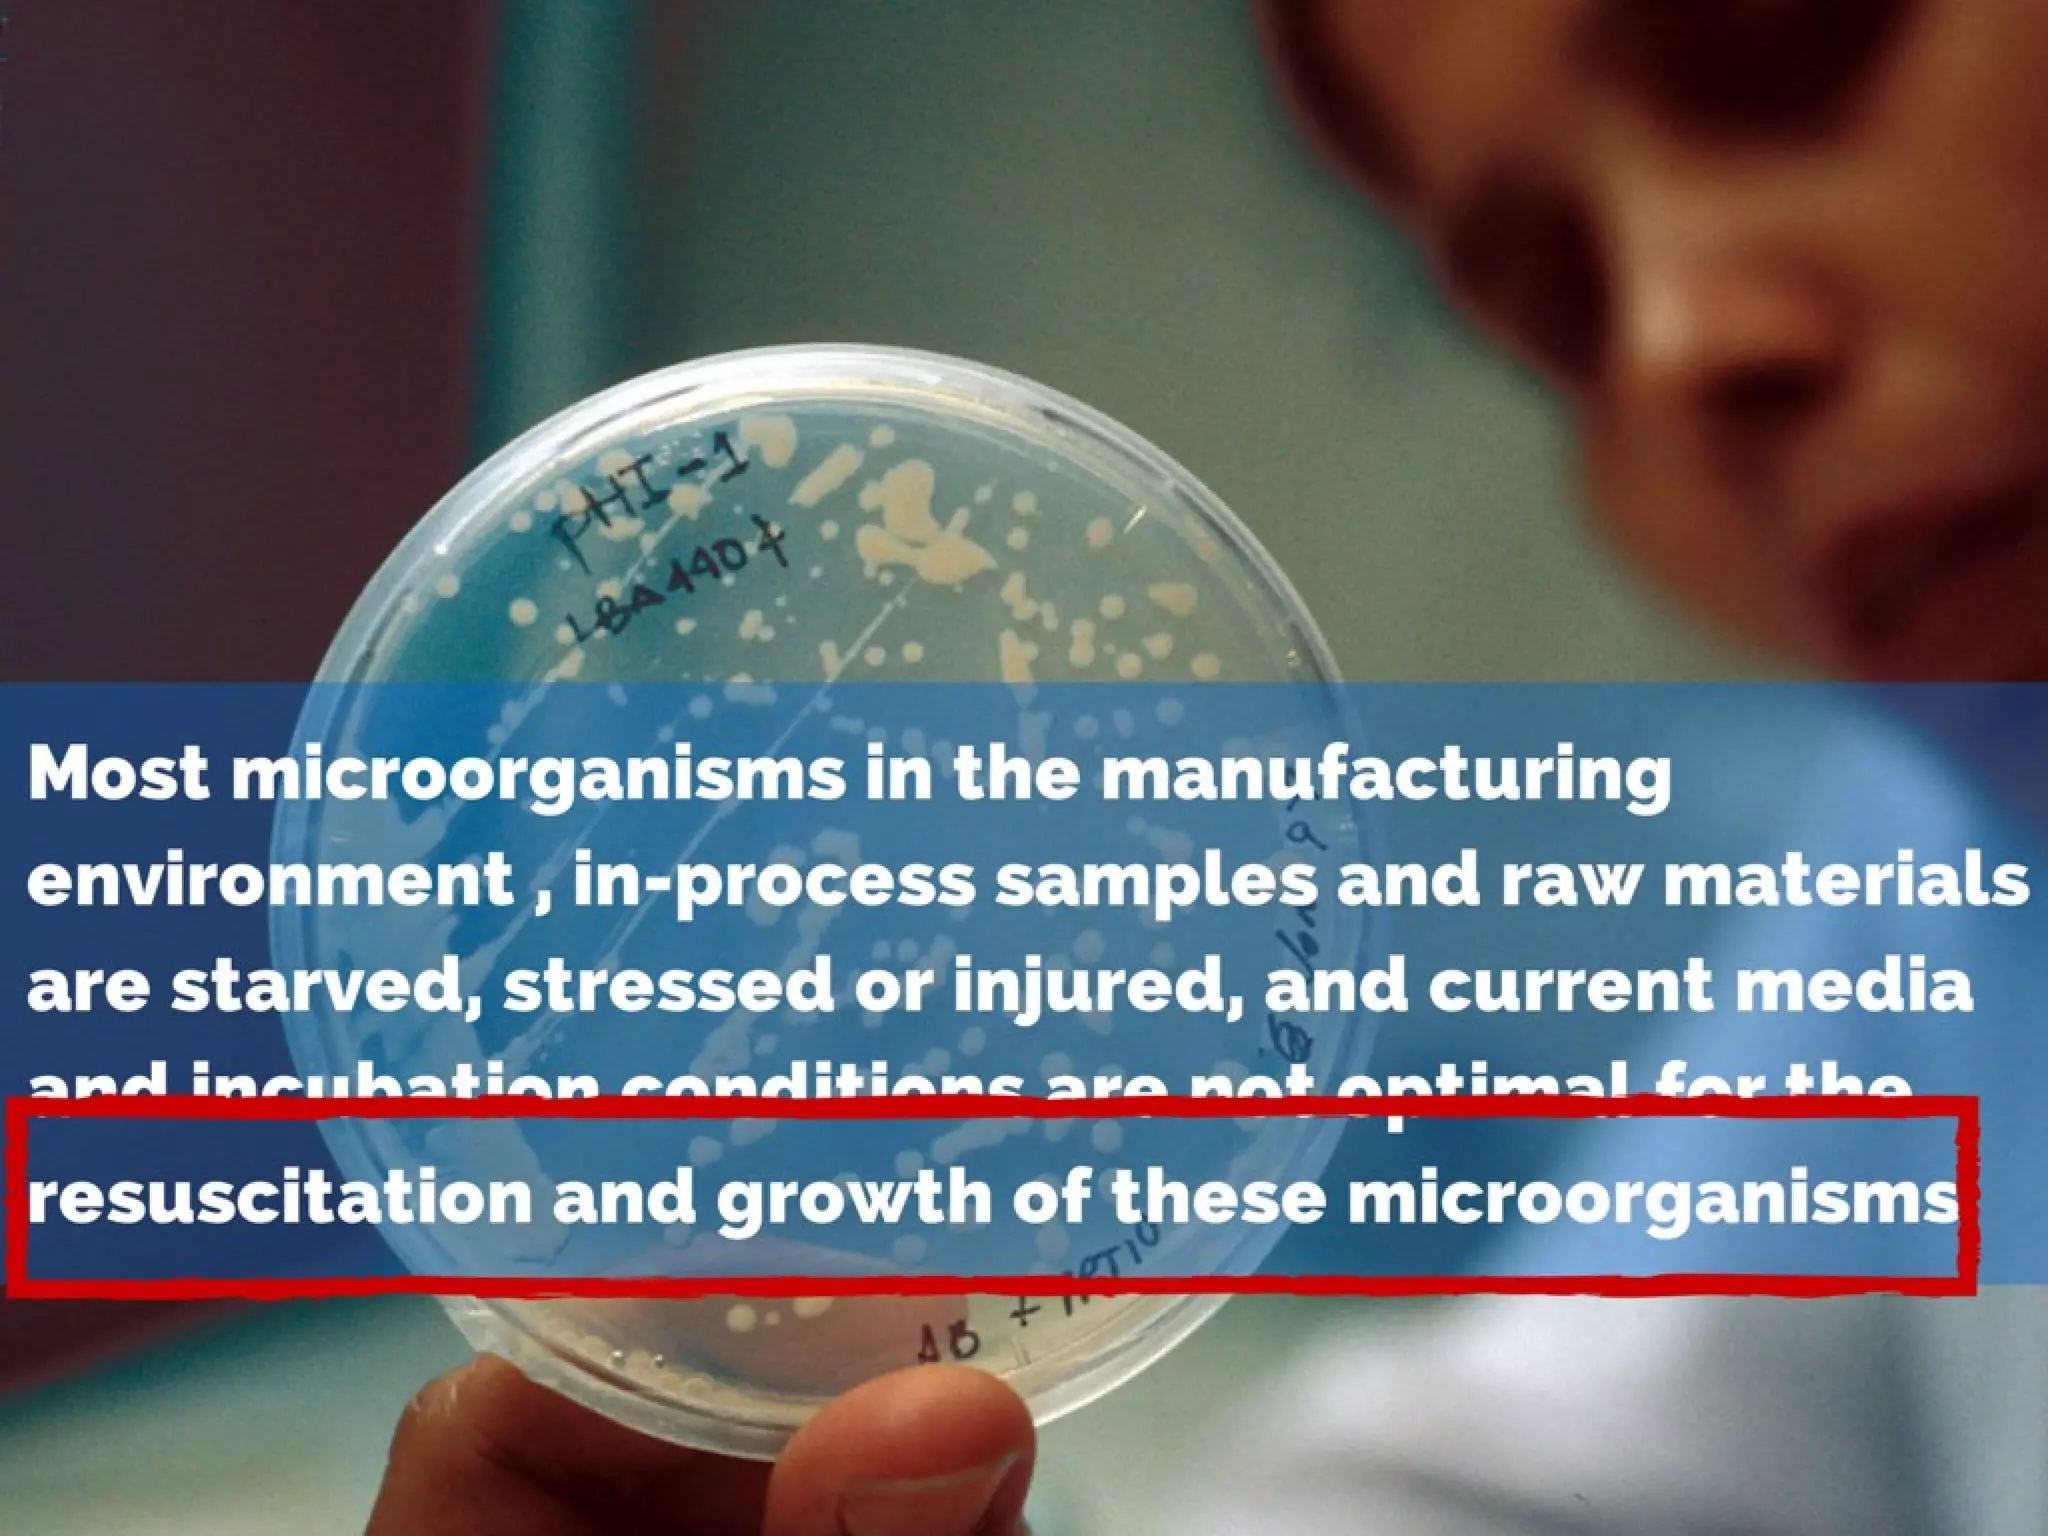

The document outlines methodologies for detecting Salmonella in various food samples, primarily focusing on incubation times, culture media, and biochemical confirmation tests. It includes specific protocols for raw flesh foods, highly contaminated foods, and animal feeds, as well as details on using chromogenic media to distinguish microorganisms based on enzymatic reactions. Additionally, it presents a range of biochemical tests and the Himedia product line for microbiological media tailored to different organisms.